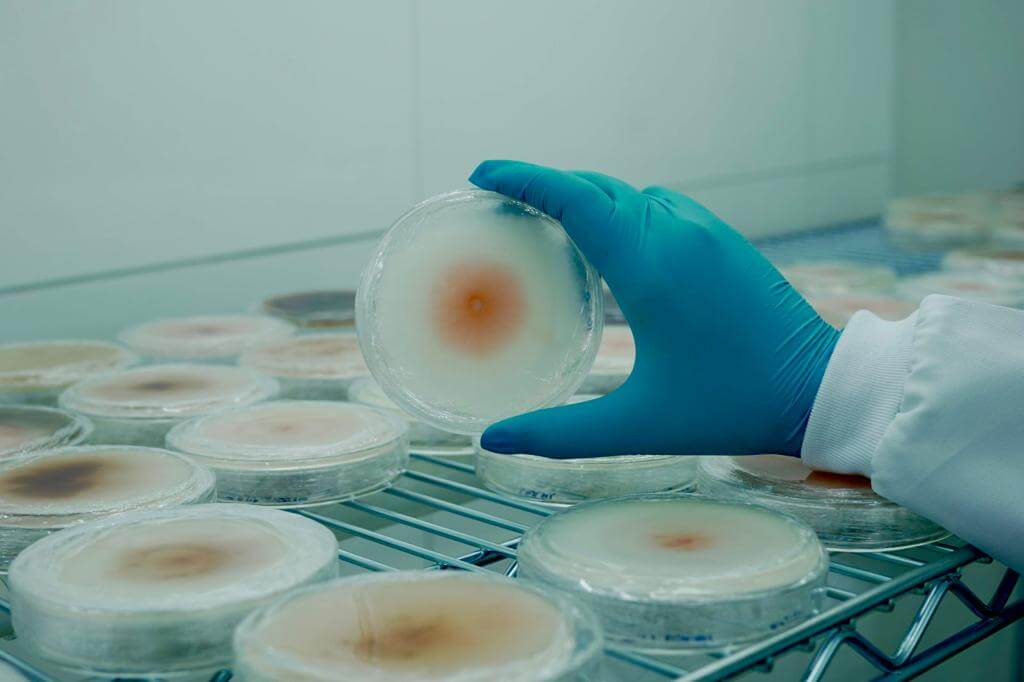
Sempre Agtech investe em defensivos biológicos e biodirigidos

Avanço dos defensivos biodiridos será apresentado pela Sempre Agtech no Congresso da ANDAV 2023
Empresa referência em melhoramento genético, pesquisa e desenvolvimento de biotecnologias investe em produtos mais sustentáveis
Sempre Agtech investe em defensivos biológicos e biodirigidos e apresenta um portfólio repleto de tecnologias com mais de 20 anos dedicados ao melhoramento genético de plantas, pesquisa e desenvolvimento de biotecnologias sustentáveis durante a realização do 12º congresso ANDAV (Associação Nacional dos Distribuidores de Insumos Agrícolas e Veterinários) que acontece entre os dias 8 e 10 de agosto, na Transamerica Expo Center, em São Paulo.
“O congresso da ANDAV reúne os principais agentes do sistema de distribuição de insumos agropecuários do Brasil, sendo uma importante oportunidade para apresentar a esse público toda nossa tecnologia voltada a uma agricultura mais moderna e sustentável”, destaca José Marcio Sutil, vice-presidente da Sempre AgTech. “Uma empresa que traz no seu DNA a pesquisa e busca permanentemente aplicar os mais altos padrões de tecnologia não pode ficar de fora de um evento que conecta um setor tão importante da cadeia produtiva nacional”, completa.
Com sede em Chapecó (SC), a Sempre é uma empresa 100% brasileira e está presente em todos os estados de importância agrícola do país, tendo uma sua indústria de produção de sementes em Santa Helena de Goiás, bem como, um centro de pesquisa na mesma cidade e outro em Toledo PR.
No início deste ano a nasce a WIN, que assume a responsabilidade por ser o braço de inovação e pesquisa do grupo. Está em fase de instalação como um Centro de Referência em Tecnologia dentro do Instituto de Pesquisas Tecnológicas (IPT), na capital paulista. A unidade recebeu, ao todo, mais de R$ 50 milhões em investimento.
No segmento de biológicos, a WIN tem feito pesquisa e desenvolvimento de soluções em conjunto com parceiros comerciais e instituições como a Embrapa e Esalq. A avaliação é de que, desta forma, será possível levar novos produtos para o mercado mais rapidamente e chegar a um número maior de produtores rurais.
Os produtos que estão em desenvolvimento pela WIN, atualmente, seguem três linhas: proteção de cultivos, tolerância a estresses biótico e abióticos e eficiência no uso de nutrientes, com principal foco para o nitrogênio, gerando impactos altamente positivos e diretos na agricultura tropical.
Tecnologia de RNAi
O foco da SEMPRE AgTech é a pesquisa e desenvolvimento de defensivos biodirigidos mais sustentáveis (eco-friendly), baseados na tecnologia de RNA interference (RNAi).
O método, conhecido como RNA interferente (RNAi) para sementes de milho e soja é um mecanismo natural responsável pelo silenciamento gênico que atua sobre o RNA mensageiro (mRNA). Para uso agrícola, essa tecnologia é programada para inativar genes específicos em plantas daninhas, insetos-praga e doenças, associados a processos essenciais à sua sobrevivência
De acordo com o executivo da SEMPRE, este método inovador trará benefícios de atuar somente nos alvos desejados, trazendo grande benefícios a sustentabilidade e biodiversidade. “Dessa forma o agricultor poderá controlar em sua lavoura o ataque de insetos, fungos e demais pragas que podem afetar a produtividade de forma sustentável”, diz Sutil.
SEMPRE AGTECH
A SEMPRE é uma empresa 100% nacional que há mais de 20 anos se dedica a pesquisa e desenvolvimento de híbridos e investe em defensivos biológicos e biodirigidos. Em 2008, foi criada a marca SEMPRE AgTech com foco em tecnologias agrícolas inovadoras e sustentáveis para ampliar o potencial da agricultura tropical.
Com sede em Chapecó, Santa Catarina, a Sempre está presente em todos os estados de importância em produção agrícola do país.